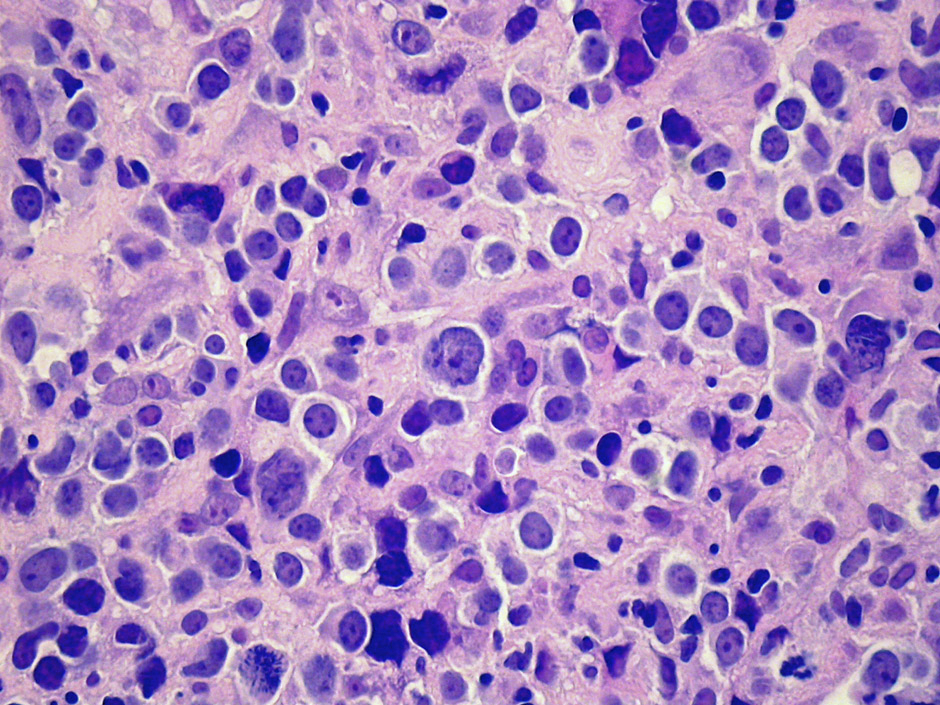

DOI: https://doi.org/10.4414/smw.2012.13511
Diffuse large B-cell lymphoma (DLBCL) is the most frequently-occurring lymphoma, accounting for an estimated 35% of all lymphoma cases worldwide. In the Western world, nearly 90% of aggressive mature B-cell lymphomas are identified as DLBCL. This heterogeneous disease has a complex classification, and if left untreated, takes an aggressive and fatal clinical course. Patients typically present with nodal or extranodal disease, usually exhibiting rapid tumour growth and symptoms that are highly dependent upon the tumour localisation.
For over 25 years, the CHOP (cyclophosphamide, doxorubicin, vincristine and prednisone) regimen was the gold standard for the treatment of DLBCL. Today, the addition of monoclonal antibodies such as rituximab (R) has altered the therapeutic landscape and improved clinical outcomes. However, despite recent advances in the classification and molecular profiling of the disease, its biological heterogeneity still hampers diagnosis, prognosis and treatment. Compounding this challenge, more than half of the patients diagnosed with DLBCL are over 60 years of age. Thus, today’s clinician has to walk the line between efficacy and tolerability for a disease in which many issues remain to be resolved with respect to aetiology, pathology and treatment.
The present review aims to discuss some of the key issues that affect clinical practice with respect to the diagnosis, treatment, and follow-up of DLBCL patients.
B-cell lymphomas are malignant cellular proliferations that arise at various steps during the process of normal B-cell development occurring in the primary lymphoid organs and secondary lymphoid tissues or at various non-lymphoid sites [1]. DLBCL is a large B lymphoid cell neoplasm with a diffuse growth pattern composed of large B-lymphocytes with nuclear size equal to or exceeding normal macrophage nuclei or more than twice the size of normal lymphocytes (fig. 1). Morphological, biological and clinical studies have identified distinct morphological variants, molecular and phenotypic subgroups and clinico-pathological entities amongst DLBCL [2]. Yet, most DLBCL cases would be finally classified as DLBCL not otherwise specified (NOS), not meeting the classification criteria of a specific subtype as proposed by the current World Health Organisation (WHO) system of classification [2].
Figure 1
Typical morphological appearance of DLBCL.

Figure 2
C-MYC gene rearrangement, demonstrated by a “break-apart” FISH probe. Note free green and red signals corresponding to the rearranged allele as well as fused signals corresponding to the second non-rearranged allele.
The WHO divides DLBCL into subtypes based on clinical, morphological, immunological and genetic features (table 1) [3, 4]. There are three main morphologic variants each with its own characteristic cytological parameters: centroblastic, immunoblastic and anaplastic, with the immunoblastic variant being associated with the worst prognosis [5]. Unfortunately, the identification of immunoblastic variants is often not reproducible [2]. Phenotypically, over 95% of DLBCL cases express pan-B-cell markers, such as CD20 [6]; a few phenotypic markers such as FoxP1 and Cyclin E are consistently associated with poor outcome [7]. The prognostic value of Bcl-2 expression has been abolished by the incorporation of rituximab into standard therapeutic regimens [8].
DLBCL probably arises via a stepwise process of somatic mutations, particularly chromosomal translocations involving oncogenes and, often, promoter regions of the immunoglobulin genes. The genes most commonly rearranged in DLBCL are BCL6 (over 30% of cases), BCL2 (approximately 20% of cases) and C-MYC (5–10% of cases). Somatic point mutations in other genes including CARD11, A20 and TNFRSF11A leading to NF-κB pathway activation are also observed in 10 to 20% of cases [9]. Except for rearrangements of C-MYC, all other recurrent genetic abnormalities in DLBCL have not yet been linked to a specific outcome. DLBCL with C-MYC rearrangements (fig. 2) has a poorer prognosis and is poorly responsive even to rituximab plus CHOP (R-CHOP) therapy, with approximately 50% of patients showing early relapses or progressive disease [10–12].
Gene expression profiling divides DLBCL into three molecular subtypes, germinal centre B-cell – like (GCB) DLBCL, activated B-cell – like (ABC) DLBCL and primary mediastinal B-cell lymphoma (PMBL). The GCB-like cases are associated with better prognosis and respond well to etoposide and rituximab [13], whereas ABC-like cases have a poorer prognosis but could benefit from the addition of bortezomib [14] and rituximab [15] to a CHOP-like regimen. Nevertheless, gene expression data do not capture all the biological parameters that influence diagnosis and response to therapy. Attempts at phenotypic stratification of DLBCL have failed to reliably classify the disease into GCB and ABC subtypes [16], leaving gene-profiling as the current gold standard.
The clinical variables with prognostic significance in DLBCL such as age, disease stage, serum lactate dehydrogenase (LDH) levels, performance status and extranodal involvement form the basis of the International Prognostic Index (IPI) (table 2). The IPI has prognostic value independent of molecular subtyping. Due to the importance of age in determining treatment and outcome, the age-adjusted IPI (aaIPI; table 2) is widely used in the management of elderly DLBCL patients, and includes only three of these prognostic factors (performance status, disease stage and LDH level) [17].
Currently, the only reliable diagnosis of DLBCL is obtained through tissue-based histopathological examination. Whenever possible, excisional biopsies are preferred over core needle biopsies in order to ensure sufficient tissue for morphological and molecular analysis [18]. The current ESMO guidelines also highlight the importance of obtaining enough material [19]. Once diagnosis has been established, the patient undergoes staging, which involves medical history, physical examination and blood chemistry testing including LDH and uric acid. Screening for HIV, Hepatitis B and C as well as protein electrophoresis are also recommended. In case of positivity for hepatitis B surface antigen (HBsAg) or antibodies to hepatitis B core antigen (anti-HBc), prophylactic treatment with an antiviral drug needs to be considered during and several months after treatment with immunochemotherapy regimens containing a B-cell-specific antibody, because of potentially fatal hepatitis reactivation [20].
Imaging techniques routinely used for staging prior to therapy include contrast-enhanced computed tomography (CT) and 18F-fluorodeoxyglucose positron emission tomography (18FDG-PET) scanning. ESMO guidelines suggest at least a CT scan of the chest and abdomen in patients eligible for curative therapy [19, 21], while giving a strong recommendation for the use of PET scanning to better delineate the extent of the disease [22].
The use of interim PET/CT scanning is currently the focus of many clinical trials in DLBCL. The prognostic and predictive value of this procedure may be assessed at various timepoints: at initial diagnosis, after two to four treatment cycles (interim PET/CT), at the end of treatment, in the follow up phase, at the time of relapse, after the induction of salvage treatment and after salvage high-dose therapy. PET/CTs are performed not only to improve diagnostic accuracy but are increasingly used to guide treatment decisions. Along with Hodgkin’s lymphoma, DLBCL belongs to the group of the intensely 18FDG-PET “avid” tumours [23]. Although the procedure results in upstaging of about 10–20% of the cases at initial diagnosis, this fact rarely alters the choice of treatment. Consequently, an initial PET/CT may not be absolutely necessary. However, the use of PET/CT scanning for initial staging of DLBCL is strongly recommended in current clinical guidelines [24]. In addition, since interim or later PET/CTs may become more important, nuclear medicine specialists place emphasis on the fact that images taken at initial diagnosis are mandatory or at least helpful to reliably assess PET images taken during or at the end of treatment.
The role of interim PET/CT scanning to monitor response during therapy is currently one of the most debated questions in clinical trials and has led to conflicting results [25–31]. This question was also addressed in a trial run by the Schweizerische Arbeitsgruppe für Klinische Krebsforschung (SAKK; trial 38/07). Interim results of this trial have been recently published [32]. Although a negative interim PET is strongly associated with a durable complete response, a positive PET after only two or four cycles of R-CHOP14 cannot reliably predict outcome [32]. At present, the use of interim (mid-treatment) PET/CT scanning for response assessment in DLBCL is only recommended within clinical trials [24, 33, 34].
In current daily practice, PET/CT scanning has its clearest role in restaging patients at the end of treatment. In this setting, PET/CT scanning has a high negative predictive value (between 85% to over 90%) in patients with Hodgkin’s lymphoma or DLBCL. Data from the Vancouver lymphoma group have suggested that in patients with residual abnormalities≥2 cm on conventional CT scan, PET/CT may help to select individuals who need consolidative radiation after the end of chemotherapy [35]. Studies are also underway to evaluate PET/CT scanning after the induction of salvage treatment to decide whether the use of autologous or allogeneic stem cell transplantation is more appropriate.
In conclusion, PET/CT scanning in DLBCL has been shown to be most useful at the time of initial staging and at the end of primary treatment, whereas the value of interim PET scanning to monitor response and guide treatment decisions is much less clear. In the setting of relapsed disease, PET/CT scanning may be helpful in guiding treatment approaches; however, more data are needed in order to generate reliable treatment algorithms.
| Table 1: DLBCL variants, subgroups and subtypes (from Jaffe et al. [116]). |
| DLBCL, not otherwise specified |
| Common morphologic variants: Centroblastic Immunoblastic Anaplastic Rare morphologic variants Molecular subgroups GCB ABC Primary mediastinal large cell lymphoma Immunohistochemical subgroups CD5-positive DLBCL GCB-like non-GCB – like |
| DLBCL subtypes |
| T-cell/histiocyte-rich large B-cell lymphoma Primary DLBCL of the CNS Primary cutaneous DLBCL, leg type EBV-positive DLBCL of the elderly |
| Other lymphomas of large B-cells |
| Primary mediastinal (thymic) large B-cell lymphoma Intravascular large B-cell lymphoma DLBCL associated with chronic inflammation Lymphomatoid granulomatosis ALK-positive LBCL Plasmablastic lymphoma Large B-cell lymphoma arising in HHV8-associated multicentric Castleman disease Primary effusion lymphoma |
| Table 2: The International Prognostic Index (IPI) [117] and age-adjusted IPI [118] for Non-Hodgkin’s Lymphoma. | ||
| Risk Factor | 0 Point | 1 Point |
| IPI | ||
| Age | ≤60 years | >60 years |
| Ann Arbor stage | I or II | III or IV |
| Serum LDH level | Normal | Above normal |
| Number of extranodal sites of involvement | ≤1 | >1 |
| ECOG performance status | 0–1 | ≥2 |
| aaIPI (≤60 years or >60 years) | ||
| Ann Arbor stage | I or II | III or IV |
| Serum LDH level | Normal | Above normal |
| ECOG performance status | ≤1 | >1 |
If left untreated, DLBCL has a median survival of less than 1 year [36]. Prior to the rituximab era, anthracycline-based chemotherapy regimens alongside involved-field radiation formed the basis of treatment [37, 38]. The introduction of the chimaeric monoclonal anti-CD20 antibody rituximab a decade ago was a milestone in the treatment of B-cell lymphomas including DLBCL, greatly improving progression-free survival (PFS) and overall survival (OS) [39–41].
In general, patients over 60 years are classified as elderly; this population comprises over half of those diagnosed with aggressive disease [42]. The original data illustrating the benefits of R-CHOP therapy was established in elderly patients. Based on the results of earlier Phase II trials in patients with indolent and aggressive lymphomas, the Groupe d’Etudes des Lymphomes de l’Adulte (GELA) conducted a study comparing eight cycles of R-CHOP against eight cycles of CHOP alone administered every 21 days in patients over 60 years of age. R-CHOP21 resulted in significantly higher complete response rates (76% vs. 63% for CHOP alone; P = 0.0005) and two-year OS rates (70% vs. 57% for CHOP alone; P = 0.007) [43]. These findings have been confirmed in the five- and ten-year follow-up results, which showed statistically-significant benefits in favour of R-CHOP in terms of PFS, OS, event-free survival (EFS) and disease-free survival (DFS); (P = 0.00001, P = 0.0073, P = 0.00002, P = 0.00031, respectively) [44, 45]. The GELA findings were corroborated independently in the E4494 study run by the US Intergroup [46].
The results from the RICOVER-60 trial have added new information on the R-CHOP dosing schedule [47]. The trial was based on a bifactorial design comparing six versus eight cycles of CHOP14 with or without eight cycles of rituximab in patients between 60–80 years of age. All patients received recombinant granulocyte colony-stimulating factor (G-CSF) support. The findings reported by Pfreundschuh et al. suggest that a dose-dense treatment schedule may improve outcomes, particularly in patients with poor prognosis. Six cycles of R-CHOP14 followed by two cycles of rituximab (6xR-CHOP14 + 2R) significantly improved EFS, PFS and OS compared to six cycles of CHOP14; extending chemotherapy to eight cycles conferred no additional clinical benefits. An important aspect of the RICOVER-60 trial was the high compliance to the dosing regimen (≥98% and ≥95% median relative dose for the six- and eight-cycle regimens, respectively). The introduction of pre-phase treatment (1 mg vincristine once and 100 mg prednisone daily around 1 week prior to the first CHOP cycle) has greatly minimised the first-cycle effect and tumour lysis syndrome, allowing for the successful completion of therapy in most patients [47, 48].
Although the RICOVER-60 trial was based on a dose-dense R-CHOP regimen, the superiority of R-CHOP14 versus the standard R-CHOP21 regimen still lacks formal clinical validation. Surprisingly, data from a trial by the UK NCRI do not indicate the superiority of dose-dense R-CHOP [49, 50]. Results from this trial showed no differences in either complete or overall response rates, or failure-free and overall survival. Of note, this trial was not restricted to patients between 60–80 years of age; around half of the patient cohort were younger patients between 18–60 years of age. Similarly, the recently presented second interim analysis of the LNH03-6B trial did not support the hypothesis of the higher efficacy of dose dense R-CHOP14 over R-CHOP21 with respect to EFS, PFS and OS [51]. Long-term follow up is needed before establishing a preferred dosing regimen. For the time being, both R-CHOP14 and R-CHOP21 will remain in the front line as standard-of-care therapies for patients above 60 years of age.
Several lines of evidence suggest that there is potential for improving clinical outcomes by further exploiting rituximab dosing. First, pharmacokinetic data from the RICOVER-60 trial showed that rituximab trough serum levels increased slowly and only reached a plateau after the fifth or sixth administration. The DENSE-R-CHOP14 trial explored the effect of four additional rituximab applications during the first 3 weeks to the standard regimen of eight rituximab and six CHOP14 cycles (for a total of 12 applications of rituximab). Preliminary data from this study suggest higher immediate rituximab serum levels and higher complete response rates [52]. However, these results have not been fully published yet and will need to be confirmed by independent data. Gender appears to matter in the treatment of DLBCL patients with male patients having lower rituximab trough serum levels and poorer three-year PFS (relative risk for progression 1.6; P = 0.004) compared to female patients. This question is being investigated in the ongoing DENSE-R-UP-CHOP14 study in which female patients receive 375 mg/m2 and male patients receive 500 mg/m2 [53].
The majority of clinical trials on elderly DLBCL patients have excluded patients over 80 years of age. Due to the lack of data, treatment of this group of very old patients is controversial [54]. In a retrospective analysis of patients over 80 years of age, Italiano et al. showed that the addition of rituximab to reduced-dose CHOP chemotherapy provides a good compromise between toxicity and efficacy [55]. Results from one of the first prospective studies in patients over 80 years of age combining rituximab with a dose-reduced CHOP regimen (R-miniCHOP) showed promising clinical response and two-year OS rates of 59% [56]. The only factor influencing OS was a serum albumin concentration of ≤35 g/L (hazard ratio 3.2, 95% CI 1.4–7.1; P = 0.0053). The good tolerability profile allowed the majority of patients to complete the planned treatment and supports the application of a dose-reduced chemotherapy regimen in the very elderly. The potential for achieving disease cure is still a valid option for this patient subgroup, encouraging clinicians to consider an R-CHOP – based regimen in elderly patients with good performance status. For elderly patients not eligible to receive R-CHOP therapy, exploratory studies on alternate chemotherapy partners (such as bendamustine) for rituximab have also showed promising results, though these need to be confirmed in larger numbers of patients [57].
The treatment of younger patients with DLBCL is generally stratified according to disease risk assessed by aaIPI score. In patients with no more than one risk factor according to the aaIPI, six to eight cycles of R-CHOP21 is currently the mainstay of most treatment regimens [19, 58]. In practice, many oncologists have begun using R-CHOP14 – based treatment regimens, analogous to that used in the RICOVER-60 trial. There is no evidence that the therapeutic index of this regimen is inferior to that of R-CHOP21, and furthermore the use of R-CHOP14 offers the patient a substantially shorter time on treatment (three vs. five months).
The MInT trial was one of the first studies to demonstrate the benefits of rituximab plus CHOP chemotherapy over chemotherapy alone. In this study, a total of 824 patients aged 18–60 years with 0–1 risk factors according to the aaIPI were randomised to six cycles of CHOP or CHOP-like chemotherapy, either with or without rituximab followed by radiotherapy to bulky and extranodal sites [59]. A key finding was that the incorporation of rituximab conferred significant survival benefits with respect to EFS as well as OS compared to chemotherapy alone in younger good-prognosis patients with newly diagnosed DLBCL. In a recent update, the improvement in PFS (79.9% vs. 63.8%; P <0.0001) and OS (89.8% vs. 80%; P = 0.001) for immunochemotherapy was maintained after a median follow-up of 70 months [60]. Multivariate analysis demonstrated that EFS, PFS and OS were affected not only by the addition of rituximab, but also by aaIPI score and the presence of bulky disease. Consequently, two subgroups amongst younger patients with good prognosis could be distinguished: those with a very favourable prognosis (aaIPI = 0 with no bulky disease) and a less favourable subgroup (aaIPI = 1 and/or bulky disease) [60]. Based on these results, the ongoing FLYER study (DSHNHL-2004-2) run by the German High-Grade Non-Hodgkin’s Lymphoma Study Group (DSHNHL) will test the feasibility of a dose reduction (by comparing four versus six cycles of CHOP-21 chemotherapy with six applications of rituximab in each treatment arm) in the subgroup of young patients with very favourable prognosis with the aim of reducing toxicity without compromising efficacy. Results from this trial will be complemented by the UNFOLDER study (DSHNHL-2004-3) investigating whether dose-dense application of the R-CHOP regimen every two weeks has improved efficacy compared to the standard R-CHOP-21 regimen in the less favourable prognosis subgroup.
The LNH03-2B study conducted by the GELA explored the combination of eight cycles of rituximab with an intensive ACVBP (doxorubicin, cyclophosphamide, vincristine, bleomycin and prednisone) regimen against a standard arm with eight cycles of R-CHOP21 in younger DLBCL patients with an aaIPI of 1. The rationale for this study was based on previously published findings demonstrating the superiority of ACVBP over CHOP21 alone in patients with DLBCL in the pre-rituximab era [61, 62]. Compared to patients in the R-CHOP21 arm, patients treated with R-ACVBP had significantly improved three-year EFS (80.9% vs. 66.7%, p = 0.0035), PFS (86.8% vs. 73.4%, p = 0.0015) and OS (92.2% vs. 83.8%, p = 0.0071) [63]. However, the ACVBP regimen was associated with more treatment-related toxicities, particularly Grade 3–4 haematological events. Long-term follow-up results from this study are needed before the risk-benefits of R-ACVBP versus R-CHOP can be properly assessed. Although no direct comparison between the results of this trial and the previously mentioned MInT trial can be made, it is nonetheless interesting to note that the outcome of the corresponding subgroup of patients with 1 risk factor in the MInT trial treated with only six cycles of R-CHOP21 appears to be similar to the more intensively-treated subgroup in the R-ACVBP arm and even superior to the standard arm with eight cycles of R-CHOP in the GELA study. The fact that only patients in the MInT trial received radiotherapy for bulky or extranodal disease – whereas no radiotherapy was planned in the GELA trial – raises the question on the value of radiotherapy after the full course of immunochemotherapy in DLBCL patients. The eagerly awaited UNFOLDER trial will address the role of consolidative radiotherapy in this setting.
Although it has not been formally validated, the combination of rituximab plus CHOP is accepted as the benchmark against which new dosing regimens or agents are measured [64, 65]. There is currently no consensus on the optimal treatment for younger patients with unfavourable aaIPI scores (aaIPI 2-3) and the best option for these patients is to enrol them in well-designed clinical trials. Intensified variants to the CHOP regimen have been tested, including the addition of etoposide (CHOEP21: 100 mg/m2 on days 1–3), and the use of recombinant human G-CSF alongside dose-dense CHOP14 or CHOEP14 [66]. Notably, the addition of rituximab to CHOEP or CHOP equalised the benefit of etoposide in a young, good-prognosis patient population [59]. However, in a recent population-based investigation from the Danish Lymphoma Group, the R-CHOEP14 regimen compared favourably with the R-CHOP14 regimen (without etoposide) in young high-risk patients with 2–3 risk factors according to the aaIPI (4-year OS 75% vs. 62%, p = 0.04, respectively) [67]. To assess the clinical outcome and influence of various biomarkers in a group of patients treated with dose-adjusted R-EPOCH, the CALGB is investigating germinal centre B-cell (GCB) and post-GCB subtypes by immunohistochemistry [13]. The combination of R-CHOP with bortezomib is being tested in those with the ABC subtype [14]. Dose-adjusted R-EPOCH was shown to overcome the negative prognostic value of translocated C-MYC [68]. Other dose-intensive regimens are being explored, including R-ACVBP [69, 70].
One of the most extensively debated issues in this context is the role of up-front high dose chemotherapy (HDT) followed by autologous stem cell transplantation (ASCT) for younger patients with high risk disease. A meta-analysis of 15 randomised controlled trials failed to demonstrate a clear benefit for HDT with ASCT as first-line therapy [71]. Recently, the results of four additional randomised trials incorporating rituximab have been presented. In the GOELAMS075 trial, eight cycles of R-CHOP14 resulted in a similar three-year PFS/DFS compared to rituximab plus HDT (76% vs. 83% respectively, for both treatment arms) but R-CHOP14 was better tolerated [72]. Similarly, HDT with R-MegaCHOEP14 followed by ASCT was no more effective than eight cycles of R-CHOEP14 but was associated with a much higher incidence of infections in the DSHNHL Phase III trial in young high-risk DLBCL patients with 2–3 risk factors according to the aaIPI [73]. The two-year PFS results were similar in both arms, with even superior results for the R-CHOEP14 regimen in the subgroup of patients with only 2 risk factors according to the aaIPI. Overall, the R-CHOEP14 regimen resulted in an excellent PFS (73.7%) and OS (84.6%) in this poor-prognosis population. On the basis of these encouraging results, the DSHNHL is currently investigating whether optimized rituximab administration can further improve the outcomes of the R-CHOEP14 regimen. In contrast, HDT followed by ASCT after four cycles of R-CHOP14 or R-MegaCHOP14 (R-HDC + ASCT) resulted in a superior two-year PFS compared to the pooled population of standard R-CHOP14 or R-MegaCHOP14 in the DLCL04 trial conducted by the FIL [74]. So far, this advantage in PFS has not been translated into an OS benefit and longer follow-up will be needed to clarify the role of HDT in this setting. It is noteworthy that the two-year PFS curves in both the non-ASCT arms were superimposable, showing similar results for eight cycles of R-CHOP14 and six cycles of the investigational dose-intensified R-MegaCHOP14 regimen. Finally, the results of a U.S./Canadian Intergroup trial (SWOG S9704) have recently been presented [75]. After induction therapy with five cycles of CHOP21 (± rituximab), 253 of 397 enrolled patients were randomly assigned to either three additional cycles of CHOP (± rituximab) or one additional cycle of CHOP (± rituximab) followed by HDT with ASCT. Two-year PFS was 69 and 56%, respectively [hazard ratio: 1.72; 95% CI: 1.18-2.51; p = 0.005] in favour of HDT over conventional therapy. However, there was no difference in OS between the treatment arms (71% versus 74%, respectively, p = 0.32). Exploratory analysis indicated that the majority of clinical benefits occurred in the high risk group (aaIPI = 3). Nevertheless, these conclusions should be interpreted with caution as only 44 patients in each treatment arm belonged to the latter group.
Taken together, these clinical data do not unequivocally demonstrate the superiority of consolidation therapy with HDT and ASCT as first-line therapy over six to eight cycles of CHO(E)P-like chemotherapy combined with eight doses of rituximab. In accordance with the current ESMO guidelines, these new regimens remain experimental. It is highly recommended that young patients with poor prognosis are treated within a clinical trial [19].
In patients with “limited disease” (usually defined as stage I and non-bulky stage II disease), the use of abbreviated chemotherapy followed by involved-field radiation therapy (IFRT) has been the subject of clinical trials [76]. The advantages of this abbreviated regimen are thought to be 1) decreased risk of cardiotoxic effects due to the lower total dose of doxorubicin, 2) the use of two treatments without cross-resistance, and 3) the direct application of radiotherapy to sites of disease [77]. The SWOG initially demonstrated that three cycles of CHOP followed by IFRT was superior to eight cycles of CHOP in patients with localized DLBCL in terms of five-year PFS and OS (77% vs. 64%, P = 0.03; and 82% vs. 72%, P = 0.02, respectively) [77]. However, the initial superiority of the combined approach disappeared with longer follow-up [78], indicating that the shorter duration of therapy may be associated with higher relapse rates [58]. A later study conducted by the SWOG showed that the addition of four cycles of rituximab to abbreviated CHOP in combination with IFRT resulted in even higher PFS and OS rates than CHOP alone (PFS: 93% at 2 years and 88% at 4 years; OS: 95% at 2 years and 92% at 4 years) [79]. However, in this trial a continuing pattern of relapse without a plateau in either the PFS or OS curves was noted, suggesting that the abbreviated immunochemotherapy regimen may have failed to eradicate the malignant clone. Another hypothesis raised is that limited-stage DLBCL may be a separate molecular entity from advanced-stage disease, warranting further investigation into specific treatment regimens for this subgroup of patients [79, 80].
Recently, Sehn et al. presented data from 134 patients with non-bulky, limited stage I and II disease using a PET-based approach to tailor therapy: patients with a negative PET scan (n = 103) following three cycles of R-CHOP received only one additional cycle of R-CHOP, whereas PET-positive patients received IFRT. After a median follow-up of 30 months, seven of 103 patients have relapsed and the three-year OS was 96%. However, in the group of patients with a positive PET scan after three cycles of R-CHOP, treatment with IFRT was unsatisfactory with high (9/30 patients) distant relapse rates [81]. The results from this publication suggest that in those with localized disease, PET scanning might aid in identifying patients who may benefit from abbreviated chemotherapy. However, the appropriate treatment for patients with a positive PET scan after immunochemotherapy remains to be validated.
There is much controversy over the benefits of radiotherapy in the treatment of DLBCL. Radiotherapy has generally been used in combination with chemotherapy either with or without rituximab for the treatment of patients with localised disease. Two randomised studies showed that consolidation RT can improve EFS and OS in patients with stage I/II disease. The SWOG study (discussed above) was one of the first to show the potential benefits of three cycles of CHOP followed by IFRT in patients with stage I or non-bulky stage II disease [77]. These results have been supported independently in a retrospective analysis by the British Columbia Cancer Agency (BCCA) [82]. In contrast, a GELA trial (93-4) in elderly patients (>60 years) did not establish any benefits for the addition of IFRT to four cycles of CHOP [83]. In a separate study conducted by the GELA, ACVBP alone was shown to be superior to IFRT plus CHOP in a group of younger patients with localised disease [62], though this regimen has not been widely implemented due to increased toxicity [84].
The conflict surrounding the use of radiotherapy is partly a result of key unanswered questions on the biology of DLBCL. What are the clinical definitions for “limited stage”, “early-stage” or “localised” disease? There is currently great heterogeneity amongst the patient populations included in these clinical trials. Patients within the stage I-II categories have dramatically different survival outcomes: those with stage I or IE disease respond well regardless of therapeutic regimen, whereas those with bulky (any mass >10 cm) Stage II disease resemble those with advanced disease in terms of prognosis and treatment outcomes [84].
The results of the MInT trial for young, good prognosis patients offer some insight into the role of radiotherapy in the treatment of this subgroup. The study cohort as defined by stage, IPI risk factors and bulky disease included patients with bulky stage I or stage II–IV disease (with 0–1 aaIPI risk factors). Radiotherapy at doses of 30–40 Gray was given to patients with bulky disease (defined as more than 5 cm in diameter). Retrospective subgroup analysis showed that the most favourable subset (those with no risk factors or bulky disease) had a 90% survival without radiotherapy. Bulky disease emerged as a strong independent prognostic factor for EFS, PFS and OS, even though patients with bulky disease received additional radiotherapy [59, 85]. A historical comparison of two DSHNHL studies conducted in elderly patients showed no benefits of additional radiotherapy in patients with bulky disease who had already achieved complete response after six cycles of R-CHOP14. However, radiotherapy may be beneficial in elderly patients with bulky disease achieving only a partial remission after completion of immunochemotherapy [86]. As discussed in the previous section, the superiority of the MInT trial results (where patients with bulky disease received radiotherapy) against those of the LNH03-2B trial (no radiotherapy used) continues to fuel the radiotherapy debate. The UNFOLDER study will provide further insight into the role of consolidative radiotherapy for bulky and/or extranodal disease.
Additional efforts are underway exploring the use of PET scanning to focus radiation therapy on PET-positive residual masses. Recently, Sehn et al. reported on a series of 196 patients with advanced-stage disease who had residual abnormalities >2 cm on end-of-treatment CT scans after 6–8 cycles of R-CHOP immunochemotherapy. All patients underwent additional PET scanning. Patients with a negative PET scan were observed (regardless of initial or residual bulk), while patients with a positive PET scan received consolidative radiation therapy to the PET-positive sites: this resulted in an outcome similar to those with a negative PET upon completion of R-CHOP therapy [35]. This observation suggests a role for PET-guided consolidative radiotherapy for patients with residual masses on end-of-treatment imaging following immunochemotherapy.
Despite the improved efficacy of first-line treatment regimens, a significant proportion of patients experience disease progression or relapse. The outlook for this subgroup is dismal, with a median survival time of 6 months or less [87, 88]. The standard approach to relapsing DLBCL is high-dose therapy and autologous stem cell transplantation (SCT). Prior to the rituximab era, results from the PARMA trial demonstrated improved event-free survival (EFS) and OS in chemosensitive patients who received a platinum and cytarabine-based chemotherapy regimen (DHAP) in combination with autologous SCT, compared to those who received DHAP treatment alone [89, 90]. Since then, additional salvage regimens have been explored either alone or with the use of rituximab, including ESHAP [91, 92] EPOCH [93], CEPP [94, 95] and ICE [96, 97].
The clinical impact of relapsing disease has been re-evaluated in the rituximab era. The high efficacy of R-CHOP as a first-line therapy has led to a smaller proportion of relapses, but those who relapse present a significant clinical challenge. The choice of salvage therapy in patients who failed first-line therapy was explored in the Phase III CORAL trial [98]. A total of 396 relapsing DLBCL patients were randomised to receive three courses of either R-ICE or R-DHAP salvage therapy; responders were given HDT and autologous SCT. No significant differences were seen between R-ICE and R-DHAP in terms of overall response rates, three-year PFS and OS. Multivariate analysis revealed three main factors that influenced OS: second-line aaIPI ≥2, relapse occurring <12 months after first-line treatment, and prior rituximab exposure. Interestingly, the retrospective evaluation of the prognostic value of the cell of origin using the Hans algorithm revealed that patients with GCB-like DLBCL had an improved outcome with regards to PFS and OS when treated with R-DHAP compared with R-ICE. The independent prognostic impact of the cell of origin interaction with treatment was confirmed in multivariate analysis. These results demonstrate that the cell of origin is an important predictive factor for the response to non-anthracycline-based immunochemotherapy salvage regimens in patients with relapsed/ refractory DLBCL [99].
The poor results of standard high dose therapy (HDT) plus autologous SCT – particularly for rituximab-pretreated patients with only about 20% achieving long-term second remissions [98] – underscore the need for new treatment strategies for patients who relapse after front-line and salvage rituximab-containing therapy. A plethora of new therapeutic agents targeting the various pathways linked to the pathogenesis of DLBCL are currently under investigation [100]. However, detailed discussion of these is beyond the scope of this review.
Allogeneic SCT is being explored as an alternative in the subset of patients who relapse after first-line therapy and who do not respond to salvage regimens. In general, this treatment is reserved only for patients with poor prognosis, refractory disease, or who have failed autologous SCT [101]. Although some studies have shown lower relapse rates and better survival outcomes for allogeneic compared to autologous SCT, the high treatment-related mortality underlies the reluctance of clinicians to recommend this for all but a small subset of patients [102]. Recently, the use of reduced-intensity conditioning regimens has shown promising results [103, 104], but the optimal dosing schedules remain to be defined. A French study in 68 patients who had failed two therapeutic regimens prior to undergoing reduced-intensity conditioning followed by allogeneic SCT yielded two-year OS, PFS and relapse rates of 49%, 44% and 41%, respectively [105]. Interestingly, multivariate analysis revealed that prior anti-CD20 therapy did not affect the incidence of disease progression or relapse following the transplant. Allogeneic SCT is associated with a graft-versus-lymphoma effect that could reduce the chances of post-transplantation relapse [88], but the final outcome is heavily dependent upon tumour histology [106]. Thus, the question of optimal patient selection based on disease characteristics is a major barrier to establishing the efficacy of allogeneic SCT and the appropriate conditioning regimens.
Relapsing patients who are not eligible for transplant pose a significant clinical challenge, as few treatment options are available. Currently, several alternative salvage regimens are being explored. The use of six to eight cycles of rituximab in combination with gemcitabine-based regimens has shown encouraging results [107, 108]. However, the same patterns emerge, with non-responders faring poorly (OS for relapsed elderly patients <1 year). Similar to the situation in post-transplant survival, the degree of chemosensitivity is the primary factor dictating clinical outcomes following salvage therapy. In the rituximab era, patients experiencing relapse likely harbour disease with a distinct molecular signature requiring novel therapeutic agents. Patients falling into this category are recommended to receive treatment within a clinical trial.
Secondary involvement of the central nervous system (CNS) in DLBCL is an infrequent event with usually fatal consequences. The incidence is between 4–8% [109–111]. Evaluation of the cerebrospinal fluid by flow cytometry combined with conventional cytology greatly increases the rate of detection of clinically occult leptomeningeal disease, compared to assessment by conventional cytology only [112]. A work-up with examination of the cerebrospinal fluid is usually recommended in patients with paranasal sinus, testicular, epidural, or bone marrow involvement or if more than two extranodal sites are involved.
With no effective therapies available for CNS relapse, many experts advocate the use of prophylactic therapy for high-risk patients. Authorities including ESMO, BCCA, and the National Cancer Comprehensive Network (NCCN) recommend the routine use of CNS prophylaxis in high-risk populations [19], but there is no clear consensus on the type of therapy. The analysis of the RICOVER-60 patient cohort suggested that intrathecal methotrexate played no part in preventing CNS disease in patients who had been treated with immunochemotherapy, except in patients with testicular lymphoma [113]. More recently, the role of systemic chemotherapeutic drugs able to cross the blood-brain barrier (in particular high- or intermediate-dose methotrexate) has been emphasized supported by some data from clinical trials [114, 115]. Some studies have shown CNS relapse rates of 2–3% in patients receiving intrathecal or high-dose methotrexate, compared to 5–8% in those who received only immunochemotherapy without CNS prophylaxis [116]. On the basis of the current data, there is a rationale favouring the use of systemic high-dose methotrexate over intrathecal methotrexate for CNS prophylaxis in high-risk patients [117]. However, the optimal prophylactic regimen as well as more accurate predictors of CNS relapse need to be identified before any progress can be made with respect to the prevention of secondary CNS disease.
The widespread use of rituximab in front-line treatment regimens may affect the incidence of CNS relapse. Analysis of CNS events in the RICOVER-60 patient cohort suggested that the incorporation of rituximab to CHOP reduced the risk of CNS involvement [113], a finding that has been supported by some groups [118] and challenged by others [119]. Recent data suggests that the protective effect is most apparent in patients achieving a complete remission with R-CHOP immunochemotherapy indicating that the beneficial effect of rituximab may be through improved control and eradication of systemic disease [118]. Some of the reasons for the conflicting views stem from the heterogeneity in the different study populations, variations in front-line and prophylactic regimens, and a lack of agreement as to which subgroup of patients should receive CNS prophylaxis [109, 110, 120]. Consistently emerging risk factors for CNS relapse include high IPI score, involvement of more than one extranodal site, poor performance status, elevated LDH levels, and involvement of testes, orbit or paranasal sinuses [113, 118, 120].
During therapy, prophylaxis and treatment of systemic infections are key to improving patient outcomes. Chemotherapy-induced myelosuppression leading to severe neutropenia greatly increases the risk of infectious complications and might compromise the dose intensity of the curative treatment [121]. The intensity of the chemotherapy regimen, presence of advanced disease, co-morbidities and age are amongst the risk factors associated with the likelihood of developing febrile neutropenia. The American Society for Clinical Oncology (ASCO) and the European Organisation for Research and Treatment of Cancer (EORTC) have included the use of G-CSF in their guidelines for the supportive treatment of high-risk patients [122, 123]. As febrile neutropenic events are more likely to occur during the early cycles of chemotherapy, G-CSF should be given early in the course of treatment [124]. The DSHNHL recommends the use of acyclovir and cotrimoxazole [21, 47].
At the end of therapy, a complete restaging is performed. According to ESMO guidelines and a recent review, PET scanning is highly recommended for post-treatment assessment [24]. Bone marrow aspirate and biopsy should only be repeated at the end of treatment if initially involved.
There are no formally established guidelines on the specific procedures recommended for response evaluation and follow-up. In general, patient follow-up procedures are similar after first-line as well as after relapse treatment. ESMO guidelines recommend the patient to undergo medical history and physical examinations every three months for the first year after therapy, then every 6 months for the following two years and once a year thereafter [19]. Although repeat CT scanning at 6, 12 and 24 months after end of treatment is common practice, there is no definitive evidence that routine imaging for patients in complete remission provides any outcome advantage [19, 121]. As the majority of relapses occur during the first two years following therapy, careful clinical assessment during this time window is critical in order to catch any signs of disease progression.
The outlook for patients with DLBCL has improved, with survival rates nearly doubling over the past ten years. The introduction of rituximab to established chemotherapy regimens such as CHOP and ACVBP was a major breakthrough, allowing many patients to achieve disease cure. The clinician, however, must continue to navigate through the maze of new dosing regimens while balancing the patient’s clinical status alongside unresolved issues in lymphoma biology. There is room for improvement, particularly in the treatment of the elderly and those with high-risk disease. Future improvements in clinical outcomes depend upon acquiring a greater understanding of the pathogenesis of DLBCL. Indeed, the differing sensitivities of patients with the same stage of lymphoma to a single treatment regimen underscore the fact that there are additional parameters governing response to treatment not captured by our current system of classification. New combinations of antibodies with improved biological activity or new drugs that act in concert with R-CHOP-like regimens may help to target highly malignant tumour cells that are characteristic of high-risk disease. Additional correlations between biological parameters, therapeutic response and clinical outcomes need to be incorporated into future clinical trials to pave the way for biology-driven DLBCL therapy.
1 Nogai H, Dorken B, Lenz G. Pathogenesis of Non-Hodgkin’s Lymphoma. J Clin Oncol. 2011;29:1803–11.
2 Swerdlow SH, Campo E, Harris NL, et al. WHO Classification of Tumours of Haematopoietic and Lymphoid Tissue (IARC WHO Classification of Tumours). World Health Organization. 2008; 4th edition.
3 Campo E, Swerdlow SH, Harris NL, et al. The 2008 WHO classification of lymphoid neoplasms and beyond: evolving concepts and practical applications. Blood. 2011;117:5019–32.
4 Turner JJ, Hughes AM, Kricker A, et al. WHO non-Hodgkin’s lymphoma classification by criterion-based report review followed by targeted pathology review: an effective strategy for epidemiology studies. Cancer Epidemiol Biomarkers Prev. 2005;14:2213–9.
5 Ott G, Ziepert M, Klapper W, et al. Immunoblastic morphology but not the immunohistochemical GCB/nonGCB classifier predicts outcome in diffuse large B-cell lymphoma in the RICOVER-60 trial of the DSHNHL. Blood. 2010;116:4916–25.
6 Adams H, Liebisch P, Schmid P, et al. Diagnostic utility of the B-cell lineage markers CD20, CD79a, PAX5, and CD19 in paraffin-embedded tissues from lymphoid neoplasms. Appl Immunohistochem Mol Morphol. 2009;17:96–101.
7 Tzankov A, Zlobec I, Went P, et al. Prognostic immunophenotypic biomarker studies in diffuse large B cell lymphoma with special emphasis on rational determination of cut-off scores. Leuk Lymphoma. 2010;51:199–212.
8 Mounier N, Briere J, Gisselbrecht C, et al. Rituximab plus CHOP (R-CHOP) overcomes bcl-2-associated resistance to chemotherapy in elderly patients with diffuse large B-cell lymphoma (DLBCL). Blood. 2003;101:4279–84.
9 Lenz G, Staudt LM. Aggressive lymphomas. N Engl J Med. 2010;362:1417–29.
10 Barrans S, Crouch S, Smith A, et al. Rearrangement of MYC is associated with poor prognosis in patients with diffuse large B-cell lymphoma treated in the era of rituximab. J Clin Oncol. 2010;28:3360–5.
11 Obermann EC, Csato M, Dirnhofer S, et al. Aberrations of the MYC gene in unselected cases of diffuse large B-cell lymphoma are rare and unpredictable by morphological or immunohistochemical assessment. J Clin Pathol. 2009;62:754–56.
12 Savage KJ, Johnson NA, Ben-Neriah S, et al. MYC gene rearrangements are associated with a poor prognosis in diffuse large B-cell lymphoma patients treated with R-CHOP chemotherapy. Blood. 2009;114:3533–7.
13 Wilson WH, Dunleavy K, Pittaluga S, et al. Phase II study of dose-adjusted EPOCH and rituximab in untreated diffuse large B-cell lymphoma with analysis of germinal center and post-germinal center biomarkers. J Clin Oncol. 2008;26:2717–24.
14 Dunleavy K, Pittaluga S, Czuczman MS, et al. Differential efficacy of bortezomib plus chemotherapy within molecular subtypes of diffuse large B-cell lymphoma. Blood. 2009;113:6069–76.
15 Fu K, Weisenburger DD, Choi WW, et al. Addition of rituximab to standard chemotherapy improves the survival of both the germinal center B-cell-like and non-germinal center B-cell-like subtypes of diffuse large B-cell lymphoma. J Clin Oncol. 2008;26:4587–94.
16 Gutierrez-Garcia G, Cardesa-Salzmann T, Climent F, et al. Gene-expression profiling and not immunophenotypic algorithms predicts prognosis in patients with diffuse large B-cell lymphoma treated with immunochemotherapy. Blood. 2011;117:4836–43.
17 A predictive model for aggressive non-Hodgkin’s lymphoma. The International Non-Hodgkin’s Lymphoma Prognostic Factors Project. N Engl J Med. 1993;329:987–94.
18 Gascoyne RD. Establishing the diagnosis of lymphoma: from initial biopsy to clinical staging. Oncology (Williston Park). 1998;12:11–6.
19 Tilly H, Dreyling M. Diffuse large B-cell non-Hodgkin’s lymphoma: ESMO Clinical Practice Guidelines for diagnosis, treatment and follow-up. Ann Oncol. 2010;21(Suppl 5):v172–v174.
20 Niitsu N, Hagiwara Y, Tanae K, et al. Prospective analysis of hepatitis B virus reactivation in patients with diffuse large B-cell lymphoma after rituximab combination chemotherapy. J Clin Oncol. 2010;28:5097–100.
21 Pfreundschuh M. How I treat elderly patients with diffuse large B-cell lymphoma. Blood. 2010;116:5103–10.
22 Schaefer NG, Hany TF, Taverna C, et al. Non-Hodgkin lymphoma and Hodgkin disease: coregistered FDG PET and CT at staging and restaging – do we need contrast-enhanced CT? Radiology. 2004;232:823–9.
23 Cheson BD, Pfistner B, Juweid ME, et al. Revised response criteria for malignant lymphoma. J Clin Oncol. 2007;25:579–86.
24 Cheson BD. Role of functional imaging in the management of lymphoma. J Clin Oncol. 2011;29:1844–54.
25 Cashen A, Dehdashti F, Luo J, et al. Poor predictive value of FDG-PET/CT performed after 2 cycles of R-CHOP in patients with Diffuse Large B-Cell Lymphoma (DLCL). Blood (ASH Annual Meeting Abstracts). 2008;112:Abstract 371.
26 Gigli F, Nassi L, Negri M, et al. Interim 18f[FDG] positron emission tomography in patients with diffuse large B-cell lymphoma. Blood (ASH Annual Meeting Abstracts). 2008;112:Abstract 3609.
27 Haioun C, Itti E, Rahmouni A, et al. [18F]fluoro-2-deoxy-D-glucose positron emission tomography (FDG-PET) in aggressive lymphoma: an early prognostic tool for predicting patient outcome. Blood. 2005;106:1376–81.
28 Mikhaeel NG, Hutchings M, Fields PA, et al. FDG-PET after two to three cycles of chemotherapy predicts progression-free and overall survival in high-grade non-Hodgkin lymphoma. Ann Oncol. 2005;16:1514–23.
29 Pregno P, Chiappella A, Bello M, et al. Interim 18-FDG-Positron Emission Tomography/Computed Tomography (PET) failed to predict different outcome in Diffuse Large B-Cell Lymphoma (DLBCL) patients treated with rituximab-CHOP. Blood (ASH Annual Meeting Abstracts). 2009;114:Abstract 99.
30 Safar V, Dupuis J, Jardin F, et al. Early 18fluorodeoxyglucose PET scan as a prognostic tool in diffuse large B-cell lymphoma patients treated with an anthracycline-based chemotherapy plus rituximab. Blood (ASH Annual Meeting Abstracts). 2009;114:Abstract 98.
31 Spaepen K, Stroobants S, Dupont P, et al. Early restaging positron emission tomography with ( 18)F-fluorodeoxyglucose predicts outcome in patients with aggressive non-Hodgkin’s lymphoma. Ann Oncol. 2002;13:1356–63.
32 Mamot C, Klingbiel D, Renner C, et al. First results of a prospective evaluation of interim PET in patients with DLBCL treated with R-CHOP-14 (SAKK 38/07). Ann Oncol. 2011;22(Suppl 4):218.
33 Wagner-Johnston ND, Bartlett NL. Role of routine imaging in lymphoma. J Natl Compr Canc Netw. 2011;9:575–84.
34 Cheson BD. New response criteria for lymphomas in clinical trials. Ann Oncol. 2008;19(Suppl 4):iv35–iv38.
35 Sehn L, Hoskins P, Klasa R, et al. FDG-PET scan guided consolidative radiation therapy optimizes outcome in patients with advanced-stage diffuse large B-cell lymphoma (DLBCL) with residual abnormalities on CT Scan Following R-CHOP. Blood (ASH Annual Meeting Abstracts). 2010;116:Abstract 854.
36 Fisher RI, Miller TP, O’Connor OA. Diffuse aggressive lymphoma. Hematology Am Soc Hematol Educ Program. 2004;221–36.
37 Cabanillas F. Front-line management of diffuse large B cell lymphoma. Curr Opin Oncol. 2010;22:642–5.
38 Fisher RI, Gaynor ER, Dahlberg S, et al. Comparison of a standard regimen (CHOP) with three intensive chemotherapy regimens for advanced non-Hodgkin’s lymphoma. N Engl J Med. 1993;328:1002–6.
39 Coiffier B, Haioun C, Ketterer N, et al. Rituximab (anti-CD20 monoclonal antibody) for the treatment of patients with relapsing or refractory aggressive lymphoma: a multicenter phase II study. Blood. 1998;92:1927–32.
40 Maloney DG, Grillo-Lopez AJ, White CA, et al. IDEC-C2B8 (Rituximab) anti-CD20 monoclonal antibody therapy in patients with relapsed low-grade non-Hodgkin’s lymphoma. Blood. 1997;90:2188–95.
41 McLaughlin P, Grillo-Lopez AJ, Link BK, et al. Rituximab chimeric anti-CD20 monoclonal antibody therapy for relapsed indolent lymphoma: half of patients respond to a four-dose treatment program. J Clin Oncol. 1998;16:2825–33.
42 Coiffier B. State-of-the-art therapeutics: diffuse large B-cell lymphoma. J Clin Oncol. 2005;23:6387–93.
43 Coiffier B, Lepage E, Briere J, et al. CHOP chemotherapy plus rituximab compared with CHOP alone in elderly patients with diffuse large-B-cell lymphoma. N Engl J Med. 2002;346:235–42.
44 Feugier P, Van HA, Sebban C, et al. Long-term results of the R-CHOP study in the treatment of elderly patients with diffuse large B-cell lymphoma: a study by the Groupe d’Etude des Lymphomes de l’Adulte. J Clin Oncol. 2005;23:4117–26.
45 Coiffier B, Thieblemont C, Van Den Neste E, et al. Long-term outcome of patients in the LNH-98.5 trial, the first randomized study comparing rituximab-CHOP to standard CHOP chemotherapy in DLBCL patients: a study by the Groupe d’Etudes des Lymphomes de l’Adulte. Blood. 2010;116:2040–5.
46 Habermann TM, Weller EA, Morrison VA, et al. Rituximab-CHOP versus CHOP alone or with maintenance rituximab in older patients with diffuse large B-cell lymphoma. J Clin Oncol. 2006;24:3121–7.
47 Pfreundschuh M, Schubert J, Ziepert M, et al. Six versus eight cycles of bi-weekly CHOP-14 with or without rituximab in elderly patients with aggressive CD20+ B-cell lymphomas: a randomised controlled trial (RICOVER-60). Lancet Oncol. 2008;9:105–16.
48 Pfreundschuh M, Trumper L, Kloess M, et al. Two-weekly or 3-weekly CHOP chemotherapy with or without etoposide for the treatment of elderly patients with aggressive lymphomas: results of the NHL-B2 trial of the DSHNHL. Blood. 2004;104:634–41.
49 Cunningham D, Smith P, Mouncey W, et al. A phase III trial comparing R-CHOP 14 and R-CHOP 21 for the treatment of patients with newly diagnosed diffuse large B-cell non-Hodgkin's lymphoma. J Clin Oncol. (Meeting Abstracts). 2009;27:Abstract 8506.
50 Cunningham D, Smith P, Mouncey P, et al. R-CHOP14 versus R-CHOP21: Result of a randomized phase III trial for the treatment of patients with newly diagnosed diffuse large B-cell non-Hodgkin lymphoma. J Clin Oncol (meeting abstracts). 2011;29:abstract 8000.
51 Delarue R, Tilly H, Salles G, et al. R-CHOP14 compared to R-CHOP21 in elderly patients with diffuse large B-cell lymphoma (DLBCL): results of the second interim analysis of the LNH03-6B GELA study. Ann Oncol. 2011;22(Suppl. 4):Abstract 106.
52 Pfreundschuh M, Zeynalova S, Poeschel V, et al. Dose-dense rituximab improves outcome of elderly patients with poor-prognosis Diffuse Large B-Cell Lymphoma (DLBCL): Results of the DENSE-R-CHOP-14 trial of the German High-Grade Non-Hodgkin Lymphoma Study Group (DSHNHL). Blood (ASH annual meeting abstracts). 2007;110:abstract 789.
53 Pfreundschuh M, Murawski N, Zeynalova S, et al. Male Sex Is Associated with Lower Rituximab Trough Serum Levels and Evolves as a Significant Prognostic Factor in Elderly Patients with DLBCL Treated with R-CHOP: Results from 4 prospective trials of the German High-Grade Non-Hodgkin-Lymphoma Study Group (DSHNHL). Blood (ASH Annual Meeting Abstracts). 2009;114:Abstract 3715.
54 Ribera JM. Hope for very elderly patients with diffuse large B-cell lymphoma. Lancet Oncol. 2011;12:412–3.
55 Italiano A, Jardin F, Peyrade F, et al. Adapted CHOP plus rituximab in non-Hodgkin’s lymphoma in patients over 80 years old. Haematologica. 2005;90:1281–3.
56 Peyrade F, Jardin F, Thieblemont C, et al. Attenuated immunochemotherapy regimen (R-miniCHOP) in elderly patients older than 80 years with diffuse large B-cell lymphoma: a multicentre, single-arm, phase 2 trial. Lancet Oncol. 2011;12:460–8.
57 Weidmann E, Neumann A, Fauth F, et al. Phase II study of bendamustine in combination with rituximab as first-line treatment in patients 80 years or older with aggressive B-cell lymphomas. Ann Oncol. 2011;22:1839–44.
58 Flowers CR, Sinha R, Vose JM. Improving outcomes for patients with diffuse large B-cell lymphoma. CA Cancer J Clin. 2010;60:393–408.
59 Pfreundschuh M, Trumper L, Osterborg A, et al. CHOP-like chemotherapy plus rituximab versus CHOP-like chemotherapy alone in young patients with good-prognosis diffuse large-B-cell lymphoma: a randomised controlled trial by the MabThera International Trial (MInT) Group. Lancet Oncol. 2006;7:379–91.
60 Pfreundschuh M, Kuhnt E, Trumper L, et al. CHOP-like chemotherapy with or without rituximab in young patients with good-prognosis diffuse large-B-cell lymphoma: 6-year results of an open-label randomised study of the MabThera International Trial (MInT) Group. Lancet Oncol. 2011;12:1013–21.
61 Tilly H, Lepage E, Coiffier B, et al. Intensive conventional chemotherapy (ACVBP regimen) compared with standard CHOP for poor-prognosis aggressive non-Hodgkin lymphoma. Blood. 2003;102:4284–9.
62 Reyes F, Lepage E, Ganem G, et al. ACVBP versus CHOP plus radiotherapy for localized aggressive lymphoma. N Engl J Med. 2005;352:1197–205.
63 Recher C, Coiffier B, Haioun C, et al. Intensified chemotherapy with ACVBP plus rituximab versus standard CHOP plus rituximab for the treatment of diffuse large B-cell lymphoma (LNH03-2B): an open-label randomised phase 3 trial. Lancet. 2011;378:1858–67.
64 Brusamolino E, Rusconi C, Montalbetti L, et al. Dose-dense R-CHOP-14 supported by pegfilgrastim in patients with diffuse large B-cell lymphoma: a phase II study of feasibility and toxicity. Haematologica. 2006;91:496–502.
65 Halaas JL, Moskowitz CH, Horwitz S, et al. R-CHOP-14 in patients with diffuse large B-cell lymphoma: feasibility and preliminary efficacy. Leuk Lymphoma. 2005;46:541–7.
66 Wunderlich A, Kloess M, Reiser M, et al. Practicability and acute haematological toxicity of 2- and 3-weekly CHOP and CHOEP chemotherapy for aggressive non-Hodgkin's lymphoma: results from the NHL-B trial of the German High-Grade Non-Hodgkin's Lymphoma Study Group (DSHNHL). Ann Oncol. 2003;14:881–93.
67 Gang AO, Strom C, Pedersen M, et al. R-CHOEP-14 improves overall survival in young high-risk patients with diffuse large B-cell lymphoma compared with R-CHOP-14. A population-based investigation from the Danish Lymphoma Group. Ann Oncol. 2011; Epub ahead of print.
68 Dunleavy K, Pittaluga S, Wayne S, et al. Myc + agressive B-cell lymphomas: novel therapy of untreated Burkitt lymphoma (BL) and Myc+ diffuse large B-cell lymphoma (DLBCL) with DA-EPOCH-R. Ann Oncol. 2011;22(Suppl 4):071.
69 Coiffier B, Reyes F. Best treatment of aggressive non-Hodgkin’s lymphoma: a French perspective. Oncology. (Williston Park). 2005;19:7–15.
70 Fitoussi O, Belhadj K, Mounier N, et al. Survival impact of rituximab combined with ACVBP and upfront consolidative autotransplantation in high risk diffuse large B-cell lymphoma for GELA. Haematologica. 2011;96:1136–43.
71 Greb A, Bohlius J, Schiefer D, et al. High-dose chemotherapy with autologous stem cell transplantation in the first line treatment of aggressive non-Hodgkin lymphoma (NHL) in adults. Cochrane Database Syst Rev. 2008;1:CD004024.
72 Le Gouill S, Milpied N, Lamy T, et al. First-line rituximab (R) high-dose therapy (R-HDT) versus R-CHOP14 for young adults with diffuse large B-cell lymphoma: Preliminary results of the GOELAMS 075 prospective multicenter randomized trial. J Clin Oncol (Meeting Abstracts). 2011;29:Abstract 8003.
73 Schmitz N, Nickelsen M, Ziepert M, et al. Conventional chemoimmunotherapy (R-CHOEP-14) or high-dose therapy (R-Mega-CHOEP) for young, high-risk patients with aggressive B-cell lymphoma: Final results of the randomized Mega-CHOEP trial of the German High-Grade Non-Hodgkin Lymphona Study Group (DSHNHL). J Clin Oncol (Meeting Abstracts). 2011;29:Abstract 8002.
74 Vitolo U, Chiappella A, Brusamolino E, et al. A randomized multicentre phase III study for first line treatment of young patients with high risk (aaIPI 2-3) diffuse large B-cell lymphoma (DLBCL): Rituximab (R) plus dose-dense chemotherapy CHOP14/MegaCHOP14 with or without intensified high-dose chemotherapy (HDC) and autologous stem cell transplantation (ASCT). Ann Oncol. 2011;22(Supplement 4):Abstract 072.
75 Stiff PJ, Unger JM, Cook J, et al. Randomized phase III U.S./Canadian intergroup trial (SWOG S9704) comparing CHOP ± R for eight cycles to CHOP ± R for six cycles followed by autotransplant for patients with high-intermediate (H-Int) or high IPI grade diffuse aggressive non-Hodgkin lymphoma (NHL). J Clin Oncol (Meeting Abstracts). 2011;29:Abstract 8001.
76 Armitage JO. Treatment of non-Hodgkin's lymphoma. N Engl J Med. 1993;328:1023–30.
77 Miller TP, Dahlberg S, Cassady JR, et al. Chemotherapy alone compared with chemotherapy plus radiotherapy for localized intermediate- and high-grade non-Hodgkin's lymphoma. N Engl J Med. 1998;339:21–6.
78 Miller TP, LeBlanc M, Spier CM, et al. CHOP alone compared to CHOP plus radiotherapy for early stage aggressive non-Hodgkin’s lymphomas: Update of the Southwest Oncology Group (SWOG) randomized trial. Blood (ASH Annual Meeting Abstracts). 2001;98:724a.
79 Persky DO, Unger JM, Spier CM, et al. Phase II study of rituximab plus three cycles of CHOP and involved-field radiotherapy for patients with limited-stage aggressive B-cell lymphoma: Southwest Oncology Group study 0014. J Clin Oncol. 2008;26:2258–63.
80 Rosenwald A, Wright G, Chan WC, et al. The use of molecular profiling to predict survival after chemotherapy for diffuse large-B-cell lymphoma. N Engl J Med. 2002;20;346:1937–47.
81 Sehn L, Savage KJ, Hoskins P, et al. Treatment of limited-stage DLBCL can be effectively tailored using a PET-based approach. Ann Oncol. 2011;22(Suppl. 4):Abstract 028.
82 Shenkier TN, Voss N, Fairey R, et al. Brief chemotherapy and involved-region irradiation for limited-stage diffuse large-cell lymphoma: an 18-year experience from the British Columbia Cancer Agency. J Clin Oncol. 2002;20:197–204.
83 Bonnet C, Fillet G, Mounier N, et al. CHOP alone compared with CHOP plus radiotherapy for localized aggressive lymphoma in elderly patients: a study by the Groupe d'Etude des Lymphomes de l’Adulte. J Clin Oncol. 2007;25:787–92.
84 Persky DO, Miller TP. Localized large cell lymphoma: is there any need for radiation therapy? Curr Opin Oncol. 2009;21:401–6.
85 Pfreundschuh M, Ho AD, Cavallin-Stahl E, et al. Prognostic significance of maximum tumour (bulk) diameter in young patients with good-prognosis diffuse large-B-cell lymphoma treated with CHOP-like chemotherapy with or without rituximab: an exploratory analysis of the MabThera International Trial Group (MInT) study. Lancet Oncol. 2008;9:435–44.
86 Pfreundschuh M, Ziepert M, Reiser M, et al. The role of radiotherapy to bulky disease in the rituximab era: results from two prospective trials of the German High-Grade Non-Hodgkin-Lymphoma Study Group (DSHNHL) for elderly patients with DLBCL. Blood (ASH Annual Meeting Abstracts). 2008;112:Abstract 584.
87 Gisselbrecht C, Vose J, Nademanee A, et al. Radioimmunotherapy for stem cell transplantation in non-Hodgkin’s lymphoma: in pursuit of a complete response. Oncologist. 2009;14(Suppl 2):41–51.
88 Mounier N, Gisselbrecht C. Stem cell transplantation for diffuse large B-cell lymphoma patients in the rituximab era. Curr Opin Oncol. 2011;23:209–13.
89 Guglielmi C, Gomez F, Philip T, et al. Time to relapse has prognostic value in patients with aggressive lymphoma enrolled onto the Parma trial. J Clin Oncol. 1998;16:3264–9.
90 Philip T, Guglielmi C, Hagenbeek A, et al. Autologous bone marrow transplantation as compared with salvage chemotherapy in relapses of chemotherapy-sensitive non-Hodgkin’s lymphoma. N Engl J Med. 1995;333:1540–5.
91 Aviles A, Neri N, Huerta-Guzman J, et al. ESHAP versus rituximab-ESHAP in frail patients with refractory diffuse large B-cell lymphoma. Clin Lymphoma Myeloma Leuk. 2010;10:125–8.
92 Ueda K, Nannya Y, Asai T, et al. Efficacy and safety of modified rituximab-ESHAP therapy for relapsed/refractory B-cell lymphoma. J Chemother. 2010;22:54–7.
93 Garcia-Suarez J, Banas H, Arribas I, et al. Dose-adjusted EPOCH plus rituximab is an effective regimen in patients with poor-prognostic untreated diffuse large B-cell lymphoma: results from a prospective observational study. Br J Haematol. 2007;136:276–85.
94 Chao NJ, Rosenberg SA, and Horning SJ. CEPP(B): an effective and well-tolerated regimen in poor-risk, aggressive non-Hodgkin’s lymphoma. Blood. 1990;76:1293–8.
95 Cortelazzo S, Rambaldi A, Rossi A, et al. Intensification of salvage treatment with high-dose sequential chemotherapy improves the outcome of patients with refractory or relapsed aggressive non-Hodgkin’s lymphoma. Br J Haematol. 2001;114:333–41.
96 Persky DO, Moskowitz CH, Filatov A, et al. High dose chemoradiotherapy and ASCT may overcome the prognostic importance of biologic markers in relapsed/refractory Hodgkin lymphoma. Appl Immunohistochem Mol Morphol. 2010;18:35–40.
97 Simpson L, Ansell SM, Colgan JP, et al. Effectiveness of second line salvage chemotherapy with ifosfamide, carboplatin, and etoposide in patients with relapsed diffuse large B-cell lymphoma not responding to cis-platinum, cytosine arabinoside, and dexamethasone. Leuk Lymphoma. 2007;48:1332–7.
98 Gisselbrecht C, Glass B, Mounier N, et al. Salvage regimens with autologous transplantation for relapsed large B-cell lymphoma in the rituximab era. J Clin Oncol. 2010;28:4184–90.
99 Thieblemont C, Briere J, Mounier N, et al. The germinal center/activated B-cell subclassification has a prognostic impact for response to salvage therapy in relapsed/refractory diffuse large B-cell lymphoma: a bio-CORAL study. J Clin Oncol. 2011;29:4079–87.
100 Murawski N, Pfreundschuh M. New drugs for aggressive B-cell and T-cell lymphomas. Lancet Oncol. 2010;11:1074–85.
101 Khouri IF. Reduced-intensity regimens in allogeneic stem-cell transplantation for non-hodgkin lymphoma and chronic lymphocytic leukemia. Hematology Am Soc Hematol Educ Program. 2006;390–7.
102 Peniket AJ, Ruiz de Elvira MC, Taghipour G, et al. An EBMT registry matched study of allogeneic stem cell transplants for lymphoma: allogeneic transplantation is associated with a lower relapse rate but a higher procedure-related mortality rate than autologous transplantation. Bone Marrow Transplant. 2003;31:667–78.
103 Maloney D. Allogeneic transplantation following nonmyeloablative conditioning for aggressive lymphoma. Bone Marrow Transplant. 2008;42(Suppl 1):S35–S36.
104 Thomson KJ, Morris EC, Bloor A, et al. Favorable long-term survival after reduced-intensity allogeneic transplantation for multiple-relapse aggressive non-Hodgkin’s lymphoma. J Clin Oncol. 2009;27:426–32.
105 Sirvent A, Dhedin N, Michallet M, et al. Low nonrelapse mortality and prolonged long-term survival after reduced-intensity allogeneic stem cell transplantation for relapsed or refractory diffuse large B cell lymphoma: report of the Societe Francaise de Greffe de Moelle et de Therapie Cellulaire. Biol Blood Marrow Transplant. 2010;16:78–85.
106 Kenkre VP, Smith SM. Management of relapsed diffuse large B-cell lymphoma. Curr Oncol Rep. 2008;10:393–403.
107 El-Gnaoui T, Dupuis J, Belhadj K, et al. Rituximab, gemcitabine and oxaliplatin: an effective salvage regimen for patients with relapsed or refractory B-cell lymphoma not candidates for high-dose therapy. Ann Oncol. 2007;18:1363–8.
108 Lopez A, Gutierrez A, Palacios A, et al. GEMOX-R regimen is a highly effective salvage regimen in patients with refractory/relapsing diffuse large-cell lymphoma: a phase II study. Eur J Haematol. 2008;80:127–32.
109 Bjorkholm M, Hagberg H, Holte H, et al. Central nervous system occurrence in elderly patients with aggressive lymphoma and a long-term follow-up. Ann Oncol. 2007;18:1085–9.
110 Hollender A, Kvaloy S, Nome O, et al. Central nervous system involvement following diagnosis of non-Hodgkin’s lymphoma: a risk model. Ann Oncol. 2002;13:1099–107.
111 van Besien K, Ha CS, Murphy S, et al. Risk factors, treatment, and outcome of central nervous system recurrence in adults with intermediate-grade and immunoblastic lymphoma. Blood. 1998;91:1178–84.
112 Hegde U, Filie A, Little RF, et al. High incidence of occult leptomeningeal disease detected by flow cytometry in newly diagnosed aggressive B-cell lymphomas at risk for central nervous system involvement: the role of flow cytometry versus cytology. Blood. 2005;105:496–502.
113 Boehme V, Schmitz N, Zeynalova S, et al. CNS events in elderly patients with aggressive lymphoma treated with modern chemotherapy (CHOP-14) with or without rituximab: an analysis of patients treated in the RICOVER-60 trial of the German High-Grade Non-Hodgkin Lymphoma Study Group (DSHNHL). Blood. 2009;113:3896–902.
114 O’Rourke K, Morris K, Kennedy GA. Intravenous methotrexate as central nervous system (CNS) prophylaxis is associated with a low risk of CNS recurrence in high-risk patients with diffuse large B-cell lymphoma. Cancer. 2010;116:4283–90.
115 Vitolo U, Chiappella A, Ferreri AJ, et al. First-line treatment for primary testicular diffuse large B-cell lymphoma with rituximab-CHOP, CNS prophylaxis, and contralateral testis irradiation: final results of an international phase II trial. J Clin Oncol. 2011;29:2766–72.
116 Pui CH, Thiel E. Central nervous system disease in hematologic malignancies: historical perspective and practical applications. Semin Oncol. 2009;36:S2–S16.
117 Korfel A. Prevention of central nervous system relapses in diffuse large B-cell lymphoma: which patients and how? Curr Opin Oncol. 2011;23:436–40.
118 Villa D, Connors JM, Shenkier TN, et al. Incidence and risk factors for central nervous system relapse in patients with diffuse large B-cell lymphoma: the impact of the addition of rituximab to CHOP chemotherapy. Ann Oncol. 2010;21:1046–52.
119 Tai WM, Chung J, Tang PL, et al. Central nervous system (CNS) relapse in diffuse large B cell lymphoma (DLBCL): pre- and post-rituximab. Ann Hematol. 2011;90:809–18.
120 Boehme V, Zeynalova S, Kloess M, et al. Incidence and risk factors of central nervous system recurrence in aggressive lymphoma – a survey of 1693 patients treated in protocols of the German High-Grade Non-Hodgkin's Lymphoma Study Group (DSHNHL). Ann Oncol. 2007;18:149–57.
121 Saloustros E, Tryfonidis K, Georgoulias V. Prophylactic and therapeutic strategies in chemotherapy-induced neutropenia. Expert Opin Pharmacother. 2011;12:851–63.
122 Smith TJ, Khatcheressian J, Lyman GH, et al. 2006 update of recommendations for the use of white blood cell growth factors: an evidence-based clinical practice guideline. J Clin Oncol. 2006;24:3187–205.
123 Aapro MS, Bohlius J, Cameron DA, et al. 2010 update of EORTC guidelines for the use of granulocyte-colony stimulating factor to reduce the incidence of chemotherapy-induced febrile neutropenia in adult patients with lymphoproliferative disorders and solid tumours. Eur J Cancer. 2011;47:8–32.
124 Repetto L, Biganzoli L, Koehne CH, et al. EORTC Cancer in the Elderly Task Force guidelines for the use of colony-stimulating factors in elderly patients with cancer. Eur J Cancer. 2003;39:2264–72.
Funding / potential competing interests: This work was supported by Roche Pharma (Schweiz) AG, Reinach, Switzerland.